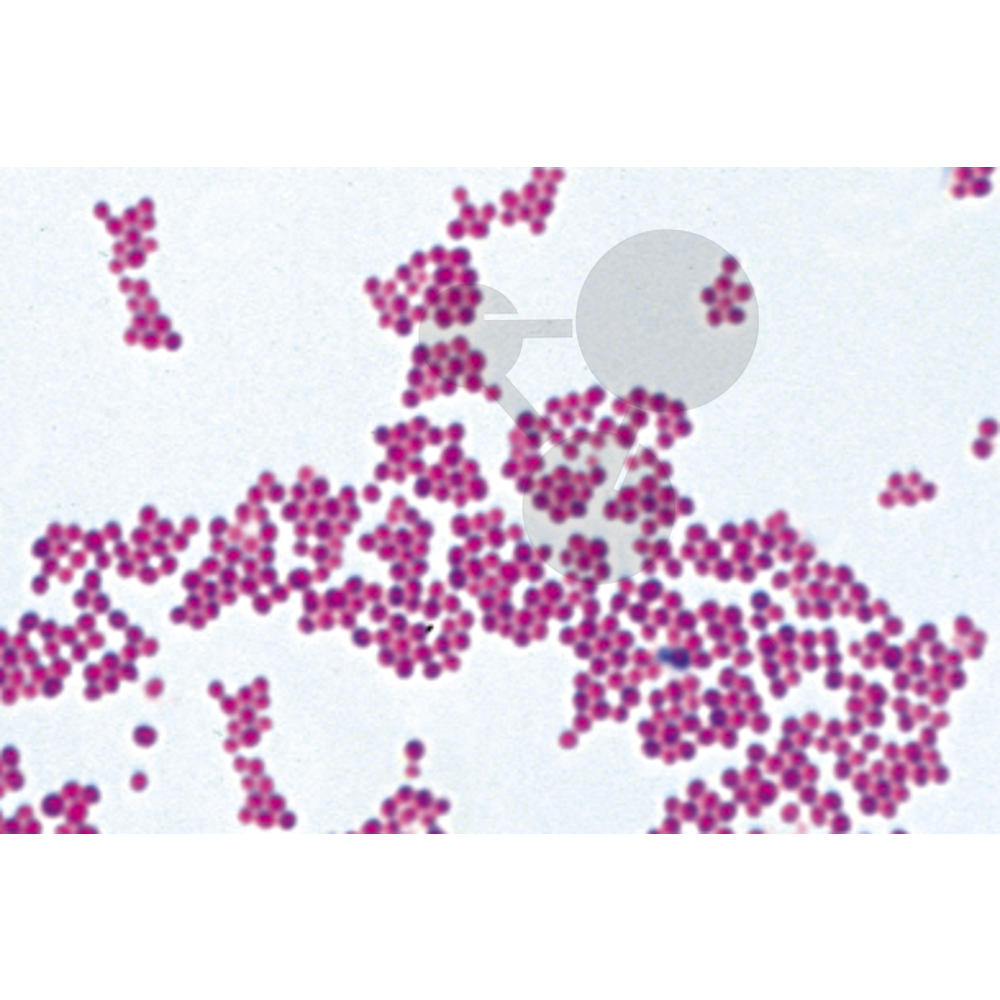

- Úvod
- Biológia, Prírodoveda
- Mikroskopy, pozorovanie
- Baktérie, 25 preparátov
Baktérie, 25 preparátov
- Kompletné špecifikácie
Baktérie, 25 preparátov510,45 EUR/ ks415,00 EUR bez DPH
Baktérie, 25 preparátov510,45 EUR/ ks415,00 EUR bez DPH
Kompletné špecifikácie
Baktérie, 25 preparátov
Tovar zaradený v kategóriách
